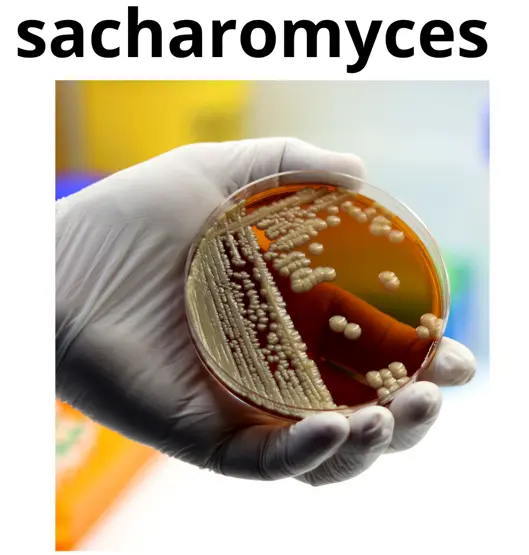
Sacharomyces

Qué son los Probióticos, beneficios y propiedades
(Creado el 17/09/206, actualizado al 10/04/2026)

Probiótico: Microorganismos vivos, que administrados en cantidades adecuadas, producen un beneficio a la salud del huésped.
Prebiótico: Son sustancias que no son digeribles y que producen un efecto beneficioso a nivel fisiológico y producen un estímulo en el crecimiento favorable o en la actividad de las bacterias autóctonas del huésped. (Son prebióticos, la oligofructosa, la inulina, la lactulosa).
Simbiótico: Hace referencia a los productos que contienen ambos, probióticos y prebióticos.
Historia de los probióticos:
Probióticos: El primer científico que propuso el uso terapéutico de las bacterias del ácido láctico (probióticos) fue Elie Metchnikoff (1845-1916, ganador del Premio Nobel por su trabajo sobre los fagocitos) luego una gran cantidad de experimentos han descrito el uso de microorganismos seleccionados, principalmente pertenecientes a la familia de bacterias del ácido láctico, para la prevención o el tratamiento de varias situaciones patológicas.
Su aislamiento de la leche rancia se realizó en 1878 por Lister, y más tarde también fueron aislados en el tracto intestinal. En 1889 se descubrió el Tissier Bifidobacterium spp. Y en 1900 Moro descubrió el Lactobacillus acidophilus. Según G. Reid los probióticos fueron utilizados primero para el alivio de los trastornos intestinales en 1906 por Tissier en una tesis en la Universidad de París.
Los primeros cultivos de Lactobacillus casei Shirota cepa se realizaron en 1930 por el Dr. Minoru Shirota (Fi en el Laboratorio de Microbiología de la Facultad de Medicina de la Universidad de Kyoto, en Japón. E
ste organismo fue aislado del intestino humano, (es resistente a los ácidos gástricos y biliares, por lo que puede llegar vivo al intestino a través de la ingesta o suplementación oral).
En 1935, el Dr. Shirota desarrollados el «Yakult», un producto lácteo fabricado con L. casei casei cepa Shirota. Planteó la hipótesis de que la ingesta diaria de este organismo podría promover la salud intestinal y prevenir las enfermedades, prolongando así la vida de las personas.
Varios estudios han demostrado que L. casei cepa Shirota y los productos lácteos fabricados con esta cepa tienen varias actividades biológicas. Ello ha dado lugar a las cepas beneficiosas de L. casei cepa Shirota y sus productos han sido denominados «probióticos«.
Cada vez más pruebas, incluyendo los estudios en humanos apoyan el papel inmunomodulador de determinadas cepas de bacterias ácido lácticas. Después de haber adquirido el carácter de GRAS, que han entrado en el campo de la inmunorregulación de las enfermedades inflamatorias crónicas y la vacunación.
Ilya Ilyich Metjnikov (se le conoce como Elie Metchnikoff, «foto») fue el primer científico en describir los efectos de los probióticos, aunque la término «probióticos» en sí no fue acuñado hasta 1965. Metjnikov escribió un libro llamado «La prolongación de la vida, en el que identificó la» autointoxicación «causada por las bacterias intestinales como principal culpable en el envejecimiento humano.
Metjnikov había visto supuestamente la longevidad y la robusta salud de algunos pueblos de Europa del Este que consumían productos lácteos fermentados a diario.
Además de los pueblos europeos del Este no eran los únicos que se alimentaban con alimentos que contenían probióticos durante siglos. Los pueblos de todo el mundo han estado consumiendo productos fermentados durante siglos, como el kimchi que es de Corea, o el kumis de los nómadas de las estepas.
Las bacterias de ácido láctico (LAB), entre las que se encuentra la especie Lactobacillus, han sido utilizadas para la conservación de alimentos mediante fermentación durante miles de años; pueden ejercer una función doble, actuando como agentes fermentadores de alimentos, pudiendo además generar efectos beneficiosos a la salud.
En términos estrictos, sin embargo, el término “probiótico” debe reservarse para los microbios vivos que han demostrado en estudios humanos controlados producir un beneficio a la salud. La fermentación de alimentos brinda perfiles de sabor característicos y reduce el pH, lo que impide la contaminación provocada por posibles patógenos.
La fermentación se utiliza a nivel mundial para el mantenimiento de una gama de materiales agrícolas sin procesar (cereales, raíces, tubérculos, frutas y hortalizas, leche, carne, pescado, etc.).
Bacterias productoras de ácido láctico (BAL)
Se trata de una clase funcional de bacterias fermentadoras no patógenas, no toxigénicas, Gram positivas, caracterizadas por producir ácido láctico a partir de carbohidratos, lo que las hace útiles para la fermentación de alimentos. En este grupo se incluyen las especies de Lactobacillus, Lactococcus, y Streptococcus thermophilus.
Dado que el género Bifidobacterium no produce la fermentación de alimentos y es taxonómicamente diferente de las otras BAL, habitualmente no se lo agrupa entre las BAL. Muchos probióticos también son BAL, pero algunos probióticos (tales como ciertas cepas de E. coli, formadoras de esporas, y levaduras usadas como probióticos) no lo son.
Fermentación
Un proceso en el cual un microorganismo transforma alimentos en otros productos, habitualmente a través de la producción de ácido láctico, etanol, y otros productos finalesacupuntura barcelona metabólicos.
A diferencia de los probióticos, la mayoría de los prebióticos se utilizan como ingredientes de alimentos en galletitas, cereales, chocolate, cremas de untar, y productos lácteos, por ejemplo. Los prebióticos mas comunes son:
- Oligofructosa
- Inulina
- Galacto-oligosacáridos
- Lactulosa
- Oligosacáridos de la leche materna
La lactulosa es un disacárido sintético utilizado como medicamento, para el tratamiento de la constipación y la encefalopatía de causa hepática.
La oligofructosa prebiótica (OF) está presente naturalmente en muchos alimentos como trigo, cebollas, bananas, miel, ajo, y puerro. La OF también se puede aislar de la raíz de achicoria o se la puede sintetizar enzimáticamente a partir de la sacarosa.
La fermentación de OF en el colon da lugar a un gran número de efectos fisiológicos, incluyendo:
- Aumento del número de bifidobacterias en el colon
- Aumento de la absorción de calcio
- Aumento del peso fecal
- Acortamiento de la duración del tránsito gastrointestinal
- Posiblemente, reduciendo los niveles de lípidos en sangre
Se supone que el aumento de bifidobacteria colónicas es beneficioso para la salud humana gracias a la producción de compuestos que inhiben a los patógenos potenciales, reduciendo los niveles sanguíneos de amoníaco, y produciendo vitaminas y enzimas digestivas.
A pesar del consenso científico existente, no hay ninguna definición legal del término probiótico. Los criterios mínimos exigidos para los productos probióticos son que el probiótico debe:
Estar especificado por género y cepa la investigación sobre cepas de probióticos específicos no puede aplicarse a cualquier producto comercializado como probiótico.
- Contener las bacterias vivas.
- Ser administrado en dosis adecuada hasta el final de su vida útil (con variabilidad mínima de un lote a otro).
- Haber demostrado ser eficaz en estudios controlados en humanos.
Desde una perspectiva científica, la descripción adecuada de un producto probiótico tal como se la expresa en la etiqueta debe incluir:
- Identificación de género y especie con nomenclatura consistente con los nombres científicos reconocidos actualmente
- Designación de la cepa
- Recuento de microrganismos viables de cada cepa al final de la vida útil
- Condiciones de almacenamiento recomendadas
- Seguridad en las condiciones de uso recomendadas
- Dosis recomendada, que debería basarse en inducción del efecto fisiológico
- Una descripción exacta del efecto fisológico, en tanto sea permitido por ley
- Información de contacto para la vigilancia post-comercialización
La interacción normal entre las bacterias intestinales y su huésped es una relación simbiótica. Se sugiere que haya una importante influencia de las bacterias del intestino superior sobre la función inmunológica por la presencia de un gran número de estructuras linfoides organizadas en la mucosa del intestino delgado (Placas de Peyer).
Su epitelio está especializado para captar y tomar muestras de antígenos, y contiene centros germinales linfoides para la inducción de respuestas de inmunidad adquirida. En el colon, los microorganismos pueden proliferar fermentando los sustratos disponibles de la dieta o las secreciones endógenas.
El intestino es el órgano relacionado con la función inmunológica más importante del organismo: aproximadamente 60 % de las células inmunológicas del organismo están presentes en la mucosa intestinal. El sistema inmune controla las respuestas inmunológicas contra:
Las proteínas de la dieta
– Prevención de alergias alimentarias
Microorganismos patógenos
– Virus (rotavirus, poliovirus)
– Bacterias (Salmonella, Listeria, Clostridium, etc.)
– Parásitos (Toxoplasma)
MECANISMOS DE LAS INTERACCIONES PROBIÓTICAS/INTERACCIONES CON EL HUÉSPED
La simbiosis entre la flora bacteriana y el huésped puede optimizarse mediante intervención farmacológica o nutricional sobre el ecosistema de los microbios intestinales usando probióticos o prebióticos.
PROBIOTICOS
Beneficios inmunológicos
- Activa los macrófagos locales para aumentar la presentación de los antígenos a los linfocitos B y aumenta la producción de inmunoglobulina A secretora (IgA) de forma local.
- Modula los perfiles de citoquinas.
- Induce disminución de la respuesta a los antígenos de los alimentos.
Beneficios no inmunológicos
- Digiere los alimentos y compite con los patógenos por los nutrientes.
- Altera el pH local para crear un ambiente local desfavorable para patógenos.
- Produce bacterioquinas para inhibir los patógenos.
- Fagocita radicales superóxidos.
- Estimula la producción epitelial de mucina.
- Aumenta la función de barrera intestinal.
- Compite por adherencia con los patógenos.
- Modifica las toxinas de origen patógeno.
PREBIÓTICOS
Efectos metabólicos: producción de ácidos grasos de cadena corta, metabolismo graso, absorción de iones (Ca, Fe, Mg)
Aumento de la inmunidad del huésped (producción de IgA, modulación de las citoquinas, etc.)
La digestión de los alimentos comienza en la boca, con la masticación de los alimentos que se descomponen en partículas más pequeñas lo que facilita que el alimento sea más fácil de digerir por las enzimas digestivas (incluidas las de la saliva) para poner en práctica.
Los alimentos pasan por el esófago hacia el estómago, donde se combina con una mezcla altamente ácida de enzimas digestivas y ácido clorhídrico. Esta mezcla se llama «quimo», es bombeada fuera del estómago hacia el intestino delgado, donde el quimo se combina con las enzimas pancreáticas y la bilis.
Es en el intestino delgado donde desglose de las proteínas, carbohidratos y grasas concluye. La mayoría de los nutrientes son absorbidos en el intestino delgado.
Entre cuatro y seis horas después de la ingestión, lo que queda de la comida pasa al intestino grueso, también conocido como colon. Aquí, los residuos se acumulan y el agua y electrolitos son absorbidos, para luego ser eliminada ésta materia fecal sale del sistema a través del recto.
La flora (microbiota intestinal) forma un ecosistema diverso y dinámico, que incluye bacterias, Archaea y Eukarya que se han adaptado a vivir en la superficie de la mucosa intestinal o dentro de la luz intestinal:
1. Estómago y duodeno
– Alojan números muy bajos de microorganismos: < 103 células bacterianas por gramo de contenido fundamentalmente lactobacilos y estreptococos.
– Las secreciones ácidas, biliares, y pancreáticas suprimen la mayoría de los microbios ingeridos
2. Yeyuno e íleon
– El número de bacterias aumenta progresivamente de aproximadamente 104 células en el yeyuno a 107 células por gramo de contenido íleon distal
3. Intestino grueso
– Densamente poblado por anaerobios: 1012 células por gramo de contenido luminal aparato digestivo.
Muchos factores, tales como la dieta, el estrés, la toma de antibióticos e incluso el envejecimiento, pueden influir en el equilibrio de estas bacterias. El equilibrio puede cambiar a favor de los microbios benéficos (que daría lugar a un pH menor o mayor acidez, un ambiente desfavorable para patógenos), o en favor de los microorganismos perjudiciales.
El gran número de microbios del tracto intestinal desempeñan un papel tanto dentro como fuera del proceso digestivo. Ayudan a completar la digestión de los componentes de los alimentos no digeridos en el intestino delgado (incluido el desglose de la lactosa o de algunas fibras no digeribles). Algunas de estas bacterias están involucradas en la producción de vitaminas.
El Dr. Robert Martindale, profesor de Cirugía en la Oregon Health and Science University, afirma que los probióticos funcionan en el tracto gastrointestinal, especialmente el de colon, por «inhibición competitiva.» Es decir, el enorme número de bacterias que crecen allí, ya sea beneficioso o perjudicial, tiene que competir para sobrevivir.
Un artículo de Goran Molin en el American Journal of Clinical of Nutrición hablaba sobre el ácido láctico de los alimentos fermentados han formado parte de los hábitos alimentarios de los seres humanos desde la antigüedad.
Molina añade que la fermentación del ácido láctico es un método muy simple de conservación de los alimentos que se pueden considerar como seguro, y antes de la Revolución Industrial, «se utilizó como forma de conservar en Europa, y aún se encuentra en África.»
El autor señala además que la evidencia arqueológica indica el uso de la fermentación del ácido láctico en los alimentos, probablemente era de origen vegetal en primer lugar, y más tarde se aplicó a los productos lácteos.
APLICACIONES DE LOS PROBIOTICOS
4 Aplicaciones clínicas según las guÍas de la OMGE
A continuación se resumen las opiniones actuales sobre las aplicaciones clínicas para varios (en orden alfabético) probióticos y prebióticos
El estudio SYNCAN evaluó el efecto de la oligofructosa más dos cepas probióticas en pacientes en riesgo de presentar cáncer de colon. Los resultados del estudio sugieren que una preparación simbiótica puede disminuir la expresión de biomarcadores para cáncer colorrectal.
Diarrea
TRATAMIENTO DE LA DIARREA AGUDA.
Se ha probado que varias cepas probióticas incluyendo L. reuteri ATCC 55730, L. rhamnosus GG, L. casei DN-114 001, y Saccharomyces cerevisiae (boulardii) sirven para reducir la severidad y duración de la diarrea infecciosa aguda en niños. La administración oral de probióticos acorta la duración de la enfermedad diarreica aguda en niños aproximadamente 1 día.
Hay varios meta análisis de ensayos clínicos controlados que muestran resultados consistentes en revisiones sistémicas, sugiriendo que los probióticos son seguros y eficaces. La evidencia que surge de los estudios en la gastroenteritis viral es más convincente que la evidencia en las infecciones bacterianas o parasitarias.
Los mecanismos de acción son específicos de cada cepa: existe evidencia de eficacia de algunas cepas de lactobacios (por ejemplo, Lactobacillus casei GG y Lactobacillus reuteri ATCC 55730) y para Saccharomyces boulardii.
PREVENCIÓN DE LA DIARREA AGUDA
Para la prevención de la diarrea en el adulto y en pediatría, solamente hay evidencia sugestiva que Lactobacillus GG, L. casei DN-114 001, y S. boulardii son eficaces en alguna situación específica.
DIARREA ASOCIADA A ANTIBIÓTICOS
En la diarrea asociada a los antibióticos existen fuertes evidencias de la eficacia de S.boulardii o L. rhamnosus GG en adultos o niños que reciben antibióticos. La investigación reciente indicó la eficacia de L. casei DN-114 001 en pacientes adultos hospitalizados para la prevención de la diarrea asociada a los antibióticos y diarrea por C. difficile.
Erradicación de Helicobacter pylori
Hay varias cepas de lactobacilos y bifidobacterias, así como Bacillus clausii, que parecen reducir efectos de la adherencia de los pacientes. Hay varias cepas que demuestran eficacia en la disminución de los efectos colaterales, pero no alteran la tasa de erradicación.
Hepatoencefalopatía
Los prebióticos como la lactulosa son usados comúnmente para la prevención y el tratamiento esta complicación de la cirrosis. Se ha logrado revertir la encefalopatía hepática mínima en 50% de los pacientes tratados con un preparado simbiótico (cuatro cepas probióticas y cuatro fibras fermentables, incluyendo inulina y almidón resistente) durante 30 días.
Respuesta inmune
Existe evidencia que varias cepas probióticas y la oligofructosa prebiótica sirven para reforzar la respuesta inmune. Hay evidencia indirecta que surge de estudios destinados a evitar la enfermedad infecciosa aguda (diarrea nosocomial en niños, episodios de influenza en invierno) y estudios que analizaron las respuestas de los anticuerpos a las vacunas.
Enfermedad Inflamatoria Intestinal (EII)
Colitis Ulcerosa
La cepa probiótica de E. coli de Nissle puede ser el equivalente a mesalazina en mantener la remisión de la colitis ulcerosa. No hay estudios adecuados que permitan asegurar que haya otros preparados probióticos que sean eficaces en la colitis ulcerosa.
Síndrome de intestino irritable (SII)
Varios estudios han demostrado importantes réditos terapéuticos con probióticos en comparación con placebo. En los estudios publicados se encuentra consistentemente una reducción de la distensión abdominal y de la flatulencia como resultado de los tratamientos con probióticos; además algunas cepas pueden mejorar el dolor y dar alivio general (B. infantis 35624).
Malabsorción de la lactosa
Streptococcus thermophilus y Lactobacillus delbrueckii subsp. Bulgaricus mejoran la digestión de la lactosa y reducen los síntomas. Esto fue confirmado en una serie de estudios controlados con individuos que consumían yogurt cultivos vivos.
Enterocolitis necrotizante
Los ensayos clínicos han demostrado que la suplementación con probióticos reduce el riesgo de enterocolitis necrotizante en recién nacidos prematuros de menos de 33 semanas. En resumen, hay evidencias sólidas para el uso de ciertas cepas probióticas en lactantes pretérmino.
Contraindicaciones:
No existen evidencias de que puedan ser nocivos usados de forma regular.
Es importante tener en cuenta que una vez abierto el frasco donde se encuentran se guarden en un lugar fresco (nevera) para evitar su deterioro.
Dedicatoria:
A la memoria del Dr. Amadeo Bosch i Noguera, fallecido a los 93 años. Fue un placer y un honor poder compartir charlas con un gran hombre y mejor persona.
Descargo de responsabilidad
Hemos realizado todos los esfuerzos posibles para garantizar que la información proporcionada sea precisa, actualizada y completa, pero no se ofrece ninguna garantía al respecto.
Esta información es un recurso de referencia diseñado como un complemento y no un sustituto de la experiencia, habilidad, conocimiento de los profesionales de la salud, ni pretende ser un diagnóstico ni una terapia referenciada.
La ausencia de una advertencia para un determinado suplemento/alimento o la combinación de los mismos no debe interpretarse de ninguna manera como una indicación de seguridad, eficacia o idoneidad para un paciente determinado.
Ultimos artículos publicados
Bibliografía:
http://www.buyprobiotics.net/education/ProBioticsForHealth/Probiotic_p01_History.shtml
http://www.thenibble.com/reviews/nutri/probiotic-food.asp
Guias practicas de la Organización Mundial de Gastroenterología (probióticos y prebióticos)
Tablas 1-2-3-4 (Artículos los probióticos, R.Amores, A.Calvo, J.R. Maestre, D.Martínez-Hernández. Departamento de Microbiología, Facultad de Medicina, Universidad Complutense de Madrid)
https://es.wikipedia.org/wiki/Categor%C3%ADa:Probi%C3%B3ticos
https://es.wikipedia.org/wiki/Ili%C3%A1_M%C3%A9chnikov